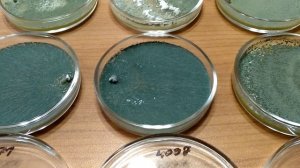
Триходерма: обзор штаммов

34:33
34:33
2025-04-17 05:41

 33:00
33:00

 33:00
33:00
2025-04-17 05:49

 24:15
24:15

 24:15
24:15
2025-04-17 05:12

 19:23
19:23

 19:23
19:23
2025-04-21 20:19

 1:19
1:19
1:19
1:19
2025-02-03 19:26

 2:03:30
2:03:30

 2:03:30
2:03:30
2026-04-24 22:00

 1:20:20
1:20:20

 1:20:20
1:20:20
2026-04-24 11:27

 3:01:31
3:01:31

 3:01:31
3:01:31
2025-10-02 19:15

 2:29:19
2:29:19

 2:29:19
2:29:19
2025-10-01 19:29

 2:36:33
2:36:33

 2:36:33
2:36:33
2026-04-24 17:06

 11:45:59
11:45:59

 11:45:59
11:45:59
2025-06-02 05:45

 2:37:06
2:37:06

 2:37:06
2:37:06
2025-12-17 16:07

 2:57:10
2:57:10

 2:57:10
2:57:10
2023-09-17 17:03

 2:45:54
2:45:54

 2:45:54
2:45:54
2025-04-13 21:30

 2:28:08
2:28:08

 2:28:08
2:28:08
2026-04-24 17:11

 2:49:04
2:49:04

 2:49:04
2:49:04
2023-09-18 20:01

 52:52
52:52

 52:52
52:52
2025-06-02 16:00

 3:48:10
3:48:10
![Esco - Нравишься (Премьера клипа 2026)]() 2:11
2:11
![Артур Пирожков - Самый красивый (Премьера клипа 2026)]() 2:16
2:16
![Дана Лахова - Сердечко (Премьера клипа 2026)]() 3:15
3:15
![StaFFорд63 - Наступит день (Премьера клипа 2026)]() 3:04
3:04
![Динара Швец - Ты мой самый лучший (Премьера клипа 2026)]() 3:27
3:27
![Владимир Ждамиров - Купола, колокола (Премьера клипа 2026)]() 4:11
4:11
![Игорь Кибирев - Уйду в туман (Премьера клипа 2026)]() 3:50
3:50
![Sabi, MIA BOYKA - Базовый минимум (Премьера клипа 2026)]() 2:26
2:26
![Надежда Мельянцева – Шапочка (Премьера клипа 2026)]() 2:41
2:41
![Сергей Одинцов - Всю любовь тебе отдам (Премьера клипа 2026)]() 3:50
3:50
![AY YOLA - Aihylyu (Премьера клипа 2026)]() 3:49
3:49
![Ислам Мальсуйгенов, Зульфия Чотчаева - Заиграла любовь (Премьера клипа 2026)]() 2:15
2:15
![Альберт Эркенов - Непокорная (Премьера клипа 2026)]() 4:04
4:04
![Zarina - Jojji Qaram (Official Video 2026)]() 3:15
3:15
![ARi SAM Vii - Я обиделась (Премьера клипа 2026)]() 2:45
2:45
![Мужик из Сибири (Александр Конев) - Хотеть не вредно (Премьера клипа 2026)]() 2:31
2:31
![Гайратжон Янгибоев & Бонухон - Шахарда (Премьера клипа 2026)]() 3:15
3:15
![Фати Царикаева - Ну и что (Премьера клипа 2026)]() 2:41
2:41
![Женя Белоусова - Мой поцелуй (Премьера клипа 2026)]() 3:20
3:20
![Рейсан Магомедкеримов - Холостой (Премьера клипа 2026)]() 2:22
2:22
![Прыгуны | Hoppers (2026)]() 1:36:21
1:36:21
![Хамнет: История, вдохновившая «Гамлета» | Hamnet (2025)]() 2:05:47
2:05:47
![Острые козырьки: Бессмертный человек | Peaky Blinders: The Immortal Man (2026)]() 1:54:08
1:54:08
![На помощь! | Send Help (2026)]() 1:52:59
1:52:59
![Военная машина | War Machine (2026)]() 1:49:24
1:49:24
![Супер Марио: Галактическое кино | The Super Mario Galaxy Movie (2026)]() 1:38:04
1:38:04
![Грозовой перевал | Wuthering Heights (2026)]() 2:16:14
2:16:14
![Я иду искать 2 | Ready or Not 2: Here I Come (2026)]() 1:47:56
1:47:56
![Грандиозная подделка | Il falsario (2025)]() 1:55:41
1:55:41
![В мгновение ока | In the Blink of an Eye (2026)]() 1:34:15
1:34:15
![Смертельно прекрасна | Pretty Lethal (2026)]() 1:30:46
1:30:46
![Обитель зла: Последняя глава | Resident Evil: The Final Chapter (2016)]() 1:46:38
1:46:38
![Шары ввех | Balls Up (2026)]() 1:46:45
1:46:45
![Семья в аренду | Rental Family (2025)]() 1:49:55
1:49:55
![Острые козырьки: Бессмертный человек | Peaky Blinders: The Immortal Man (2026)]() 1:54:08
1:54:08
![Удачи, веселья, не сдохни | Good Luck, Have Fun, Don't Die (2025)]() 2:14:31
2:14:31
![Аватар: Пламя и пепел | Avatar: Fire and Ash (2025)]() 3:17:12
3:17:12
![28 лет спустя: Часть II. Храм костей | 28 Years Later: The Bone Temple (2026)]() 1:49:24
1:49:24
![Невеста! | The Bride! (2026)]() 2:06:44
2:06:44
![Проект «Конец света» | Project Hail Mary (2026)]() 2:36:35
2:36:35
![Сборники «Оранжевая корова»]() 1:05:01
1:05:01
![Простоквашино]() 7:19
7:19
![Карли – искательница приключений. Древнее королевство]() 13:00
13:00
![Чемпионы]() 7:33
7:33
![Команда Дино. Исследователи Сезон 1]() 13:10
13:10
![Пип и Альба. Приключения в Соленой Бухте! Сезон 1]() 11:02
11:02
![Приключения Тайо]() 12:50
12:50
![Мия и Коди]() 0:12
0:12
![Роботы-пожарные]() 12:31
12:31
![Ну, погоди! Каникулы]() 7:09
7:09
![Сборники «Приключения Пети и Волка»]() 1:28:31
1:28:31
![Папа Супергерой Сезон 1]() 4:28
4:28
![Мартышкины]() 7:10
7:10
![Мотофайтеры]() 13:10
13:10
![Пакман в мире привидений]() 21:37
21:37
![Последний книжный магазин]() 11:20
11:20
![Тёплая анимация | Новая авторская анимация Союзмультфильма]() 6:46
6:46
![Зомби Дамб]() 5:14
5:14
![Лудлвилль]() 7:05
7:05
![Стражи Вселенной]() 1:04
1:04
![50 клипов шансона]() 3:12:53
3:12:53
![Лунтик | Танцы 💃💃💃 Сборник мультиков для детей]() 46:30
46:30
![Три Кота 🐱 Сборник серий подряд | Смотреть онлайн развивающие мультики и игры для детей и малышей]() 3:16:51
3:16:51
![Ми–Ми–Мишки 💫 Звездная история 🙃 Все серии ✨ Мультики для детей]() 2:10:31
2:10:31
![Хищник: Планета смерти | Predator: Badlands (2025)]() 1:47:25
1:47:25
![Bakhtin - Целовала (Премьера клипа 2023)]() 3:16
3:16
![Зверополис | Zootopia (2016)]() 1:48:48
1:48:48
![Сборник Топ 20 Номеров за 2024 год - Уральские Пельмени]() 2:52:30
2:52:30
![Давид | David (2025)]() 1:49:18
1:49:18
![Форсаж 9 | F9 (2021)]() 2:22:56
2:22:56
![Максим ФАДЕЕВ feat. Григорий ЛЕПС - Орлы или вороны ft.и]() 4:38
4:38
![Сборник На Кухне | Уральские Пельмени]() 1:30:27
1:30:27
![ТОП ЛУЧШИХ КЛИПОВ ШАНСОНА - Слушать шансон лучшее.]() 3:48:45
3:48:45
![Jakone и Kiliana - Асфальт (Mood Video)]() 2:50
2:50
![Мир в огне (все серии) 4K]() 12:26:36
12:26:36
![Аватар: Путь воды (2022)]() 3:12:39
3:12:39
![Штрафбат(1-11 серии) HD 2004]() 8:05:56
8:05:56
![КЛИПЫ 90х ⭐Русский Сборник видеоклипов]() 2:54:39
2:54:39
![ANNA ASTI - ЦАРИЦА ( Премьера клипа 2023 )]() 4:01
4:01
![СваТы 1 сезон(все серии)]() 2:17:36
2:17:36

 3:48:10
3:48:10Скачать Видео с Рутуба / RuTube
| 256x144 | ||
| 424x240 | ||
| 640x360 | ||
| 848x480 | ||
| 1280x720 | ||
| 1920x1080 |
 2:11
2:11
2026-04-08 12:00
 2:16
2:16
2026-04-20 16:39
 3:15
3:15
2026-04-21 09:41
 3:04
3:04
2026-04-23 11:16
 3:27
3:27
2026-04-09 13:37
 4:11
4:11
2026-04-17 12:33
 3:50
3:50
2026-04-21 10:26
 2:26
2:26
2026-04-23 13:18
 2:41
2:41
2026-04-03 09:19
 3:50
3:50
2026-04-21 10:41
 3:49
3:49
2026-04-20 16:46
 2:15
2:15
2026-04-17 12:38
 4:04
4:04
2026-04-10 10:01
 3:15
3:15
2026-04-20 17:11
 2:45
2:45
2026-04-12 10:21
 2:31
2:31
2026-04-08 11:47
 3:15
3:15
2026-04-20 17:02
 2:41
2:41
2026-04-10 09:47
 3:20
3:20
2026-04-15 12:53
 2:22
2:22
2026-04-11 10:26
0/0
 1:36:21
1:36:21
2026-03-27 13:35
 2:05:47
2:05:47
2026-02-06 18:40
 1:54:08
1:54:08
2026-04-13 12:20
 1:52:59
1:52:59
2026-03-27 14:10
 1:49:24
1:49:24
2026-03-10 12:44
 1:38:04
1:38:04
2026-04-12 21:37
 2:16:14
2:16:14
2026-04-20 11:54
 1:47:56
1:47:56
2026-04-12 17:20
 1:55:41
1:55:41
2026-02-26 14:41
 1:34:15
1:34:15
2026-03-01 21:54
 1:30:46
1:30:46
2026-03-28 23:09
 1:46:38
1:46:38
2026-02-25 19:41
 1:46:45
1:46:45
2026-04-22 00:25
 1:49:55
1:49:55
2026-02-13 20:27
 1:54:08
1:54:08
2026-03-21 11:57
 2:14:31
2:14:31
2026-03-12 23:32
 3:17:12
3:17:12
2026-04-02 11:34
 1:49:24
1:49:24
2026-02-19 14:08
 2:06:44
2:06:44
2026-04-22 11:21
 2:36:35
2:36:35
2026-04-11 16:06
0/0
 1:05:01
1:05:01
2025-12-12 12:24
 7:19
7:19
2026-04-03 10:14
 13:00
13:00
2024-11-28 16:19
 7:33
7:33
2026-04-15 17:25
2021-09-22 22:45
2021-09-22 23:36
 12:50
12:50
2024-12-17 13:25
 0:12
0:12
2026-04-10 14:28
2021-09-23 00:12
 7:09
7:09
2026-04-11 10:00
 1:28:31
1:28:31
2026-03-05 13:25
2021-09-22 21:52
 7:10
7:10
2025-12-30 18:33
 13:10
13:10
2024-11-27 14:57
 21:37
21:37
2024-11-28 17:35
 11:20
11:20
2025-09-12 10:05
 6:46
6:46
2026-04-25 14:53
 5:14
5:14
2024-11-28 13:12
 7:05
7:05
2025-12-30 20:49
 1:04
1:04
2026-04-14 12:27
0/0
2022-12-22 16:10
2024-08-05 22:22
 3:16:51
3:16:51
2025-10-03 19:48
2024-01-17 17:34
 1:47:25
1:47:25
2025-11-27 03:58
 3:16
3:16
2023-10-13 14:26
 1:48:48
1:48:48
2024-12-16 19:01
2025-01-13 14:00
 1:49:18
1:49:18
2026-01-29 11:25
 2:22:56
2:22:56
2023-04-25 23:06
 4:38
4:38
2017-12-19 08:20
2025-04-04 18:26
2026-02-02 14:57
 2:50
2:50
2024-07-04 15:48
 12:26:36
12:26:36
2025-11-14 19:42
2025-06-17 19:00
 8:05:56
8:05:56
2017-07-08 19:33
2022-03-11 11:17
 4:01
4:01
2023-10-12 11:54
 2:17:36
2:17:36
2025-07-24 20:55
0/0

